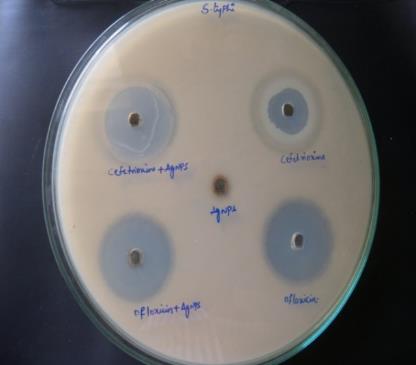

Department of Microbiology, Kakatiya University, Warangal, Telangana, India
Email: krishnagudikandula@gmail.com
Received: 24 Jun 2015 Revised and Accepted: 08 Aug 2015
ABSTRACT
Objective: In recent era, medical science has turned to a variety of novel products and technologies to halt the spread of infections. The most promising and effective antimicrobial agents being embraced by modern medical science today is silver. With increasing drug-resistance and growing concern regarding the over-prescribing of antibiotics, there has been a resurgent interest in the use of antimicrobial silver. Unlike antibiotics, silver appears to be immune to resistance. Thus, the conjugation of antibiotic with silver nanoparticles would prevent development of resistance of microbes and increase the antimicrobial property of the antibiotic.
Methods: In this manuscript, extracellular biological synthesis of silver nanoparticles was made from Trametes sp. The characterization of the nanoparticles was carried out as well as its antibiotic efficacy was evaluated in addition to the antibiotic combination.
Results: Initially the fungal cell filtrate was challenged with 1Mm AgNO3 solution, in a 250 ml Erlenmeyer flask and agitated at 30 °C in dark for 72 h under static conditions at 200 rpm and the silver nanoparticle production was monitored by the change in color and later it was subjected to optical measurements by UV-Vis spectrophotometer. The characters of these silver nanoparticles were further studied by Fourier Transform Infrared (FTIR) Spectroscopy, SEM and TEM studies. The nanoparticles produced during the study period were found to have wider antibacterial property and also it showed the enhanced efficacy in combination with ceftriaxone and ofloxacinagainst Salmonella sp.
Conclusion: The synergistic mode of antibiosis in between nanoparticles synthesized from Trametes sp. and ceftriaxone, ofloxacin was found to be more effective against Salmonella sp. in the current study.
Keywords: Trametes sp, Mycosynthesis, Silver nanoparticles, Antibacterial activity, Antibiotics.
© 2016 The Authors. Published by Innovare Academic Sciences Pvt Ltd. This is an open access article under the CC BY license (http://creativecommons.org/licenses/by/4.0/)
INTRODUCTION
Enteric fever remains an important public health problem in many countries of the world. In recent years, an increasing number of salmonellosis outbreaks have been recorded around the world, and probably there should be more cases that were not detected or reported [1]. Many different types of Salmonella exist, some of which cause illness in both animals and people, and some types cause illness in animals but not in people. The various forms of Salmonella that can infect people are referred to as serotypes, which are very closely related microorganisms that share certain structural features. Some serotypes are only present in certain parts of the world. There is considerable overlap in symptoms, although typhoid is the more severe and long-lasting disease, and is the one most likely to result in death if prompt treatment is not given. The name typhoid means 'resembling typhus' and was chosen because of the occurrence of neuropsychiatric symptoms.
Typhoid fever is endemic in developing countries, especially in Southeast Asia and Africa. Salmonella gastroenteritis is usually a self-limiting disease. Fluid and electrolyte replacement may be indicated in severe cases. Because antibiotics do not appear to shorten the duration of symptoms and may actually prolong the duration of convalescent carriage, they are not routinely used to treat uncomplicated non typhoidal Salmonella gastroenteritis. Current recommendations are that antibiotics be reserved for patients with severe disease or patients who are at a high risk for invasive disease [2]. Historically, recommended regimens for the treatment of typhoid fever included ampicillin, trimethoprim-sulfamethoxazole, or chloramphenicol. Despite the discovery of new antibiotics, treatment of intracellular infections often fails to eradicate the pathogens completely. One major reason is that many antimicrobials are difficult to transport through cell membranes and have low activity in the cells. There by imposing negligible inhibitory or bactericidal effects on the intracellular bacteria. In addition, antimicrobial toxicity to healthy tissues poses a significant limitation to their use [3]. Therefore, the delivery of the drug to the bacterial cells is currently a big challenge to the clinicians. This is on top of the problems posed by the emerging Multi-Drug Resistant species. Moreover, reduced membrane permeability of microorganisms has been cited as a key mechanism of resistance to antibiotics [4]. Emerging drug resistance over the past 40 y has limited the usefulness of these antibiotics. Presently, quinolone, macrolide, and third-generation cephalosporin antibiotics are preferred for empiric therapy pending sensitivities. Unfortunately, sensitivity to quinolones has been steadily declining; some S. enterica serovar Typhi strains resistant to fluoroquinolones have already been reported [5-7].
Further, several failures of clinical treatment of typhoid patients with ciprofloxacin and other fluoroquinolones have also been reported [8, 9]. Nanotechnology is one of the most fascinating and rapidly advancing sciences and possesses potential to revolutionize many disciplines of science, technology, medicine and agriculture if exploited properly [10]. The use of nanotechnology in medicine offers some exciting possibilities. Some techniques are only imagined, while others are at various stages of testing, or actually being used today. Rapid developments at the intersection of nanotechnology and controlled drug delivery have triggered exceptional growth in treating various diseases. As a result, over the past decade, nanotechnology has contributed tremendously to controlling drug delivery for treating various diseases, and in many cases, has led to increased activity compared to the existing drugs [11]. In recent decades, there has been increasing interest in nanotechnology from fungi, which are expected to produce high level of silver nanoparticles. Because of their rapid growth and high rate of production, fungi are used as bio-manufacturing units, which will provide an added benefit in being easy to use as compared to other microbes. The combination of antibiotics and metal nanoparticles could increase the antibiotic efficacy against resistant pathogens. Nanoparticle-antibiotic conjugates lower the amount of both agents in the concentration, which reduces harmfulness and increases antimicrobial properties. These conjugates were effective against resistant bacteria species due to this conjugation; the concentrations of antibiotics were increased at the place of antibiotic-microbe interaction and thus accelerate the binding between microbes and antibiotics [12]. For this reason, the present research was carried out for biological synthesis of nanoparticles and their use in decreasing the concentration of antibiotics. The reduction of side effects and cost-effectiveness was also considered.
The novelty of the work lies in the fact that we have used the culture filtrate to develop a simple, cost-effective, biocompatible, and an ecofriendly approach for the extracellular biological synthesis of silver nanoparticles using Trametes sp. The study involved the systematic analysis of the antibacterial activity of the biologically prepared silver nanoparticles against Salmonella sp. We also investigated the effect of the combination of antibiotics with AgNPs against Salmonella sp. It is industrially captivating and viable. This paper focuses mainly on the current research for increasing anti-salmonella performance of antibiotics by means of nanotechnology. It is clear that such systems may improve the antibiotic efficacy by increasing the drug concentration with the attachment of the nano-particles in the surrounding of the bacteria.
MATERIALS AND METHODS
Chemicals
Silver nitrate (99 % pure) was purchased from Sigma-Aldrich, India. Nutrient broth, Malt extract and glucose weresupplied by Hi-Media, India.
White rot fungi
Trametes sp. used in this study was isolated from Bodhan Forest Nizamabad District, Telangana, India. It was grown and maintained at 35 oC±2 oC on Malt Extract Agar medium (MEA: Malt extract-15 gm, NH4Cl 1 gm, K2HPO4-1 gm, Citric acid 15N per 1000 ml of distilled water).
Bacterial cultures
Salmonella typhi and Salmonella paratyphi wereprocured from the Microbial Type Collection (MTCC) center, IMTECH, Chandigargh, India.
Biosynthesis of silver nanoparticles
For the synthesis of silver nanoparticles, the white rot fungi were inoculated in MG media (Malt extract-5.0 g, Glucose-10.0 g, Distilled water-1000 ml, pH-6.0) in Erlenmeyer flasks incubated at 30 °C on a shaker (180 rpm) for 48 h. The biomass was filtered using Whatman filter paper (No.1) and the silver nanoparticles were synthesized extra cellulary by challenging the culture filtrate with 1 mM final concentration of silver nitrate AgNO3, in a 250 ml Erlenmeyer flask and agitated at 30 °C in dark for 48 h under static conditions at 200 rpm and the silver nanoparticle production was monitored. Control (without the silver ion, only culture) was also run along with the experimental flask.
Characterization of silvernano particles
UV-Vis spectroscopy analysis
UV-Vis spectral analysis was done by using (ELICO SL-159 Spectrophotometer) in the range 350-470 nm. The reduction of pure silver ions was monitored by measuring the UV-Vis spectrum of the reaction medium at 48 h of incubation.
FTIR analysis of silver nanoparticles
FTIR analysis was done using (Digital Excalibur 3000 series, Japan) in diffuse reflectance mode (DRS-800) in the range of 400-4000 cm-1 at a resolution of 4 cm-1 of the Ag-NPs from fungus extracted samples [13].
SEM analysis of silver nanoparticles
Scanning Electron Microscopic (SEM) analysis was done by (JOEL-Model 6390). Thin films of the sample were prepared on a carbon coated gird, a very small amount of the specimen on the sample holder was placed extra solution was removed using a blotting paper, and then the film on the SEM allowed to dry under a mercury lamp for 5 min.
TEM analysis of silver nanoparticles
The surface morphology and size of the nanoparticles were studied by transmission electron microscopy (JEOL (JEM-1010) instrument) with an accelerating voltage of 80 KV. Silver nanoparticles were loaded on carbon-coated copper grids, and solvent were allowed to evaporate under the infra light for 30 min. The particle size and surface morphology of nanoparticles was evaluated using Image J 1.45s software.
Antibacterial activity
The antimicrobial activity of silver nanoparticles was tested against the two pathogenic strains Salmonellatyphi and Salmonella paratyphias the method suggested by [14].For antibacterial activity agar well-diffusion method was followed, 25 ml of nutrient agar medium was poured into sterilized petri dishes. The bacterial test organisms were grown in nutrient broth for 24 h. A 100 μl nutrient broth culture of each bacterial organism (1×105 CFU/ml) were used to prepare bacterial lawns. Agar wells of 8 mm diameter were prepared with the help of a sterilized stainless steel cork borer. The wells were loaded with 60 μl of silver nanoparticles solution, 60 μl of ceftriaxone (10 mg in 100 ml of distilled water), 60 μl of ceftriaxone in combination with silver nanoparticle solution, 60 μl of ofloxicin (10 mg in 100 ml of distilled water), and 60 μl of ofloxicin in combination with the silver nanoparticle solution [15]. The plates were incubated at 37 °C for 24 h and then were observed in the presence of zones of inhibition. Each inhibition zone diameter was measured and the mean value for each organism was recorded and expressed in millimeters.
Assessment of increase in fold area
The mean of increase in fold area can be calculated by the mean surface area for the zone of inhibition of each antibiotics that has been used alone and antibiotic plus silver nanoparticle solution. The increase in the fold area of two different pathogens for antibiotics and antibiotics plus silver nanoparticle solution can be calculated by

Where, “a” and “b” refer to the zones of inhibition for antibiotic alone and antibiotic with silver nanoparticles [16].
RESULTS AND DISCUSSION
Trametes sp. used in this study was isolated from Bodhan Forest Nizamabad District, Telangana, India. For the biosynthesis of silver nanoparticles. Initially the fungal cell filtrate was challenged with 1 mM silver nitrate solution, in a 250 ml Erlenmeyer flask and agitated at 30 °C in dark for 72 h under static conditions at 200 rpm and the silver nanoparticle production was monitored by the change in color (fig. 1) and later it was subjected to optical measurements by UV-Vis spectrophotometer this analysis showed an absorbance peak at 420 nm (fig. 2), which was specific for the silver nanoparticles [17]. The exact mechanism of the synthesis of silver nanoparticles was not known, but later it was hypothesized that that the fungal biomass contain the NADH dependent nitrate reductase enzyme, when the silver ions comes in contact with the cell wall of the fungal biomass, the nitrate reductase secreted by the fungus causes the reduction of silver ions into silver nanoparticles [18-20].
FTIR analysis was used to identify the molecules, proteins and functional groups involved in the reduction of silver ions into silver nanoparticles and stabilize them as capping agent. The dried, powdered sample of silver nanoparticles showed the presence of two types of vibrations (i.e. stretching and bending) in the wavelength range of 4000 to 500 cm-1. The presence of an amine vibration band at 3400 cm-1 representing a primary amine group (N-H) stretching and amide (N-H) bending vibration bands at 1650 and 1644 cm-1 [21]. Furthermore, the FT-IR spectra of biologically synthesized silver nanoparticles also revealed peaks at 2026 and 2116 cm-1 stretching vibrations of aliphatic C-H bonds.
Fig. 1: Synthesis of silver nanoparticles from Trametes sp
Fig. 2: UV-Visible absorption spectra of silver nanoparticles after 48 h of incubation
A band at 1412 cm-1 can be assigned to CH2-scissoring stretching vibration at the planar region. Several C-N stretching, vibration peaks at 1258, 1143, 1102, 1027 and 908 cm-1 were also observed in the spectral range of 1230 to 900 cm-1 (fig. 3). In addition, the presence of bands at 1356 and 1250 cm-1 in the FT-IR spectra reveals that capping agent of biologically synthesized nanoparticles possesses an aromatic amine group with specific identities of the amide linkages between amino acid residues in the proteins in the infrared region of the electromagnetic spectrum [22]. This type of FT-IR spectra indicates the presence of a protein form of the compound on the surface of the biologically synthesized nanoparticles, confirming that metabolically produced protein acted as capping agents during production and prevented the reduced silver particle agglomeration. This evidence suggests that the release of extracellular protein molecules could possibly perform the function of formation and stabilization of silver nanoparticles in aqueous medium.
Fig. 3: FT-IR spectrum of the synthesized silver nanoparticles
The TEM technique is used to visualize the size and shape of the biosynthesized silver nanoparticles as shown in (fig. 4). The morphology of nanoparticles is highly variable with spherical shape observed on micrographs. The TEM micrograph suggests that particle diameters ranged from 5 to 40 nm which are similar to the result of [23]. SEM studies revealed that the biologically synthesized silver nanoparticles are different in size and shape and are mostly observed as individual particles and aggregates. SEM mediated characterization of biologically synthesized nanomaterials has been performed by several members. Silver nanoparticles are in the size range of 10-40 nm with a mean diameter of 14.5 nm which was revealed by particle size analysis suggesting the production of different-sized nanoparticles (fig. 5). A range of 20-50 nm particles by Lactobacillus sp. [24], 35-46 nm silver nanoparticles by Pseudomonas stutzeri [25] have been reported.
Fig. 4: SEM Micrograph of the silver nanoparticles synthesized from fungal extracts
Fig. 5: TEM Micrograph of the silver nanoparticles synthesized from fungal extracts
It is surely understood that Ag-particles and Ag-based mixes have strong antimicrobial impacts [26] and number of microorganisms have developed medication resistance over numerous eras. Up to this point, these antimicrobial specialists in view of chemicals have been viable for treatment notwithstanding, they have been restricted to use for therapeutic gadgets and in prophylaxis in antimicrobial offices. In this way, an option approach to beat the medication resistance of different microorganisms is required urgently, particularly in therapeutic gadgets, and so forth. Silver nano particles particles and silver salts have been utilized for quite a long time as antimicrobial specialists in different fields on account of their development inhibitory limit against microorganisms. The system of the inhibitory impacts of silver nano particles on microorganisms is partially known. A few studies have reported that the positive charge on the silver nano particles is significant for its antimicrobial movement through the electrostatic fascination between negative charged cell layers of microorganism and positively charged nanoparticles [27, 28]. The combined effect of these nanoparticles with antibiotics was investigated against S. typhi and S. paratyphi using the disk diffusion method. The diameter of inhibition zones (in millimeters) around the different antibiotic disks with or without silver nano particles against test strains. The anti bacterial activity of ceftriaxone and ofloxacin increase in the presence of silver nano particles against test strains the increase in synergistic effect may be caused by the bonding reaction between antibiotic and nano silver. As the antibiotic molecules contain many active groups such as hydroxyl and amido groups, which reacts easily with nano silver by chelation. More recently, Batarseh research showed that the bactericidal effect was caused by silver (I) chelating, which prevents DNA from unwinding [29]. The antibacterial activity of ceftriaxone and ofloxacin were evaluated with a diameter of inhibition zones for the test bacteria (S. typhi and S. para typhi). The antibacterial activity of ceftriaxone and ofloxacin increased significantly in the presence of silver nanoparticles (fig. 6).
Fig. 6: Antibacterial activity of silver nanoparticles produced by Trametes sp. conjugated with antibiotics against bacterial species
It was found that the silver nanoparticles produced from Trametes sp. enhanced the reaction rates of the antibiotics in a synergistic mode as well as in its own way on these pathogens. In both the cases of S. typhi and S. paratyphi the highest zone of inhibition was found in the combination of ofloxacin+silver nanoparticles followed by ceftriaxone+silver nanoparticles, ofloxicin, ceftriaxone and silver nanoparticles. (fig. 7).
Fig. 7: Graphical representation of the combination of antibiotics with silver nanoparticlesagainst the test bacteria
These results are in line with the findings of Krishna et al., [17], who mentioned increasing efficacies (percentage) of antibiotics like streptomycin and ceftriaxone when used in combination with silver nanoparticles against Bacillus subtilis, S. aureus, E. coli and Proteus vulgaris. Inanother report byShahnaz and Anima [28], studied that in vitro antibacterial activity of silver nanoparticles synthesized from Penicillium species were carried out and also in combination with the Sparfloxacin and Ofloxacin antibiotics against clinically isolated pathogens viz., Staphylococcus aureus, Bacillus cereus, E. coli, and Proteus vulgaris. It was found that the silver nano particles produced from Penicillium species enhanced the reaction rates of the antibiotics in a synergistic mode as well as in its own way on these clinically isolated pathogens. In other findings, the antibacterial activities of carbicillin and amoxicillin were amplified in the presence of silver nanoparticles against the bacterial strains. The highest increase in fold area was observed for amoxicillin against E. coli, Proteus vulgaris and Bacillus cereus. It was found that the silver nanoparticles enhanced the reaction rates of the antibiotics in a synergistic mode as well as in its own way on these clinically isolated pathogens [31]. In another study by Syed Zeeshan et al., [32], reported that the antibiotics ciprofloxacin and imipenem in combination with the silver nanoparticles and it was found to be most effective in inhibiting bacteria, if the bacteria increases its resistance to one of them, the other bactericidal agent would kill the bacteria. In synergism, the bactericidal effect is enhanced by interaction between active groups like hydroxyl and amino groups present in these antibiotics with silver nanoparticles by chelation. As a result, antibiotic-silver nanoparticles conjugate is formed in which a silver nanoparticle core is surrounded by antibiotic molecules. Thus, the antimicrobial concentration is increased at the focal site, which leads to increased destruction of bacteria[33].
From the above investigation, it was found that the silver nanoparticles synthesized from Trametes sp. along with antibiotics enhanced the antibacterial activity against test bacteria. The enhanced synergistic effect of biologically synthesized silver nanoparticles and antibiotics against pathogenic bacteria could be potentially applied in the development of new therapeutic agents.
CONCLUSION
In the present scenario, silver nanoparticles have appeared as a promising antibacterial candidate in the medical field. In this study, Trametes species were found to be an effective biological tool for the extracellular biosynthesis of stable silver nanoparticles. These biologically synthesized silver nanoparticles shows good antibacterial activity. The activity of ofloxacin and streptomycin was augmented when impregnated with silver nanoparticles.Thus, these nanoparticles can be used as antibacterial agents alone or with antibiotics and decreases the side effects. Hence, it can be concluded that the applications of silver nanoparticles and antibiotics together improved their cost-effectiveness.
ACKNOWLEDGEMENT
We acknowledge the support extended by Sophisticated Analytical Instrumentation Facility at the Department of Physics for analyzing the samples by SEM. The authors are thankful to the Ministry of Environment & Forest, New Delhi for financial support, and Head Department of Microbiology for providing laboratory facilities.
CONFLICT OF INTERESTS
The authors declare that there is no conflict of interests regarding the publication of this paper
REFERENCES